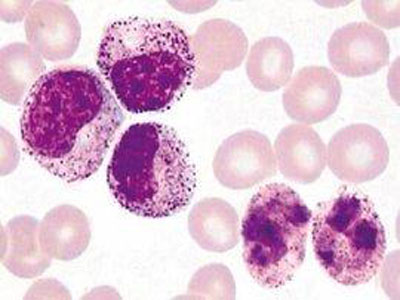
慢性白血病格列卫,慢性粒细胞白血病格列卫
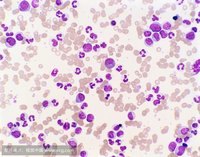
慢性白血病格列卫,慢性粒细胞白血病格列卫
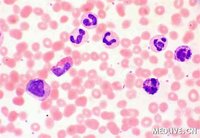
慢性白血病格列卫,慢性粒细胞白血病格列卫
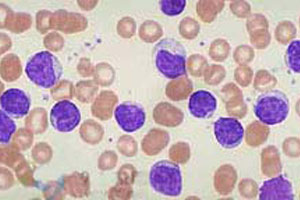
慢性白血病格列卫,慢性粒细胞白血病格列卫

20多年前,一部名为《血疑》的日本电视连续剧在国内*放播**,那个身患绝症的美丽少女的故事,牵动了无数观众的心,故事剧情跌宕起伏、扣人心弦,也让观众知道了一个血液疾病即急性白血病。几年前,我国一部名为《滚蛋吧,肿瘤君》的热门电影,让观众知道了另一个恶性血液疾病既非霍其金淋巴瘤。最近,随着《我不是药神》的放映,又一个血液疾病再次走进大众视野,它就是慢性粒细胞性白血病,以及治疗该病的一线抗肿瘤靶向药物伊马替尼(格列卫)。
在这里,我们简单回顾一下慢性粒细胞性白血病及格列卫等治疗的相关知识。

慢性粒细胞性白血病(CML、慢粒)是骨髓造血干细胞克隆性增殖形成的恶性肿瘤,占成人白血病的15%,全球年发病率为1.6~2.0/10万,异基因造血干细胞移植(allo—HSCT)是唯一有望治愈慢性粒细胞性白血病的方法,但以伊马替尼(格列卫)为代表的多种酪氨酸激酶*制剂抑**(TKI)的出现使异基因造血干细胞移植的一线治疗地位受到挑战,格列卫作为一线治疗药物使CML患者的10年生存率达85%~90%,因此目前格列卫逐步取代干细胞移植成为首选一线方案。
一、临床表现
1.慢性粒细胞性白血病可在各种年龄发病,男性略大于女性。临床分为三期:慢性期、加速期和急变期。早期常无症状,可因健康检查或其他疾病就医时发现血象异常或脾大而被确诊,随病情发展,出现乏力、低热、多汗或盗汗、体重减轻等表现,脾大可达脐或盆腔,并感左腹坠胀,多数患者有胸骨中下段压痛。白细胞极度增高时可表现为呼吸窘迫、头晕、语言不清、脑出血、阴茎异常勃起等。慢性期一般约1~4 年,以后逐渐进入加速期,进入加速期后病人常有发热、脾进行性肿大、骨痛、贫血和出血,对原药失效。急变期为慢粒的终末期,表现与急性白血病类似,预后极差,数月内死亡。

2.诊断标准:典型的临床表现,Ph染色体和(或)BCR/ABL融合基因阳性即可诊断。
二、预后评估
许多因素影响着CML患者的慢性期及生存期,比如患者年龄、白细胞计数、嗜酸粒细胞计数、肝脾大小、贫血程度、血小板计数等因素与预后密切相关。

三、治疗方案
(一)慢性期的治疗
1.酪氨酸激酶*制剂抑**治疗:慢性期治疗为酪氨酸激酶抑,首选格列卫400 mg,每日1次。治疗期间应定期监测血液学、细胞及分子遗传学反应,进行治疗反应评估,随时调整治疗方案。临床治疗反应包括最佳反应、次佳反应以及治疗失败。治疗反应次佳以及失败的患者及时行BCR/ABL激酶区突变检测,适时更换第二代酪氨酸激酶*制剂抑**,如尼洛替尼或达沙替尼,有合适供者的患者可考虑行异基因造血干细胞移植,格列卫耐受不佳者更换第二代酪氨酸激酶*制剂抑**。
2.其他治疗:干扰素为基础的方案以及异基因造血干细胞移植亦可用于慢粒慢性期的治疗。

(二)进展期的治疗
1.加速期治疗:选择适合的酪氨酸激酶*制剂抑**,如果患者有合适的造血干细胞供者来源,可考虑行异基因造血干细胞移植。存在T3151突变或第二代酪氨酸激酶*制剂抑**不敏感突变的患者应及早移植。
2.急变期治疗:选择酪氨酸激酶*制剂抑**单药或联合化疗提高诱导缓解率,缓解后应尽快行异基因造血干细胞移植、或新药试验。

四、第二代酪氨酸激酶*制剂抑**的选择
对格列卫治疗不耐受、反应欠佳或失败的患者考虑换用第二代酪氨酸激酶*制剂抑**,并根据BCR/ABL激酶突变类型,分别选择的第二代酪氨酸激酶*制剂抑**为尼洛替尼和达沙替尼。
五、异基因造血干细胞移植
六、干扰素的应用
在酪氨酸激酶*制剂抑**治疗时代,曾经的最佳治疗选择即干扰素为基础的治疗方案逐步成为二三线选择,只用于以下情况:酪氨酸激酶*制剂抑**耐药、不耐受且不适合移植的慢性期患者;各种原因暂时无法应用酪氨酸激酶*制剂抑**治疗的或无法法坚持长期使用酪氨酸激酶*制剂抑**的慢性期患者。
七、酪氨酸激酶*制剂抑**治疗期间的妊娠管理(略)。
(图片来自网络)